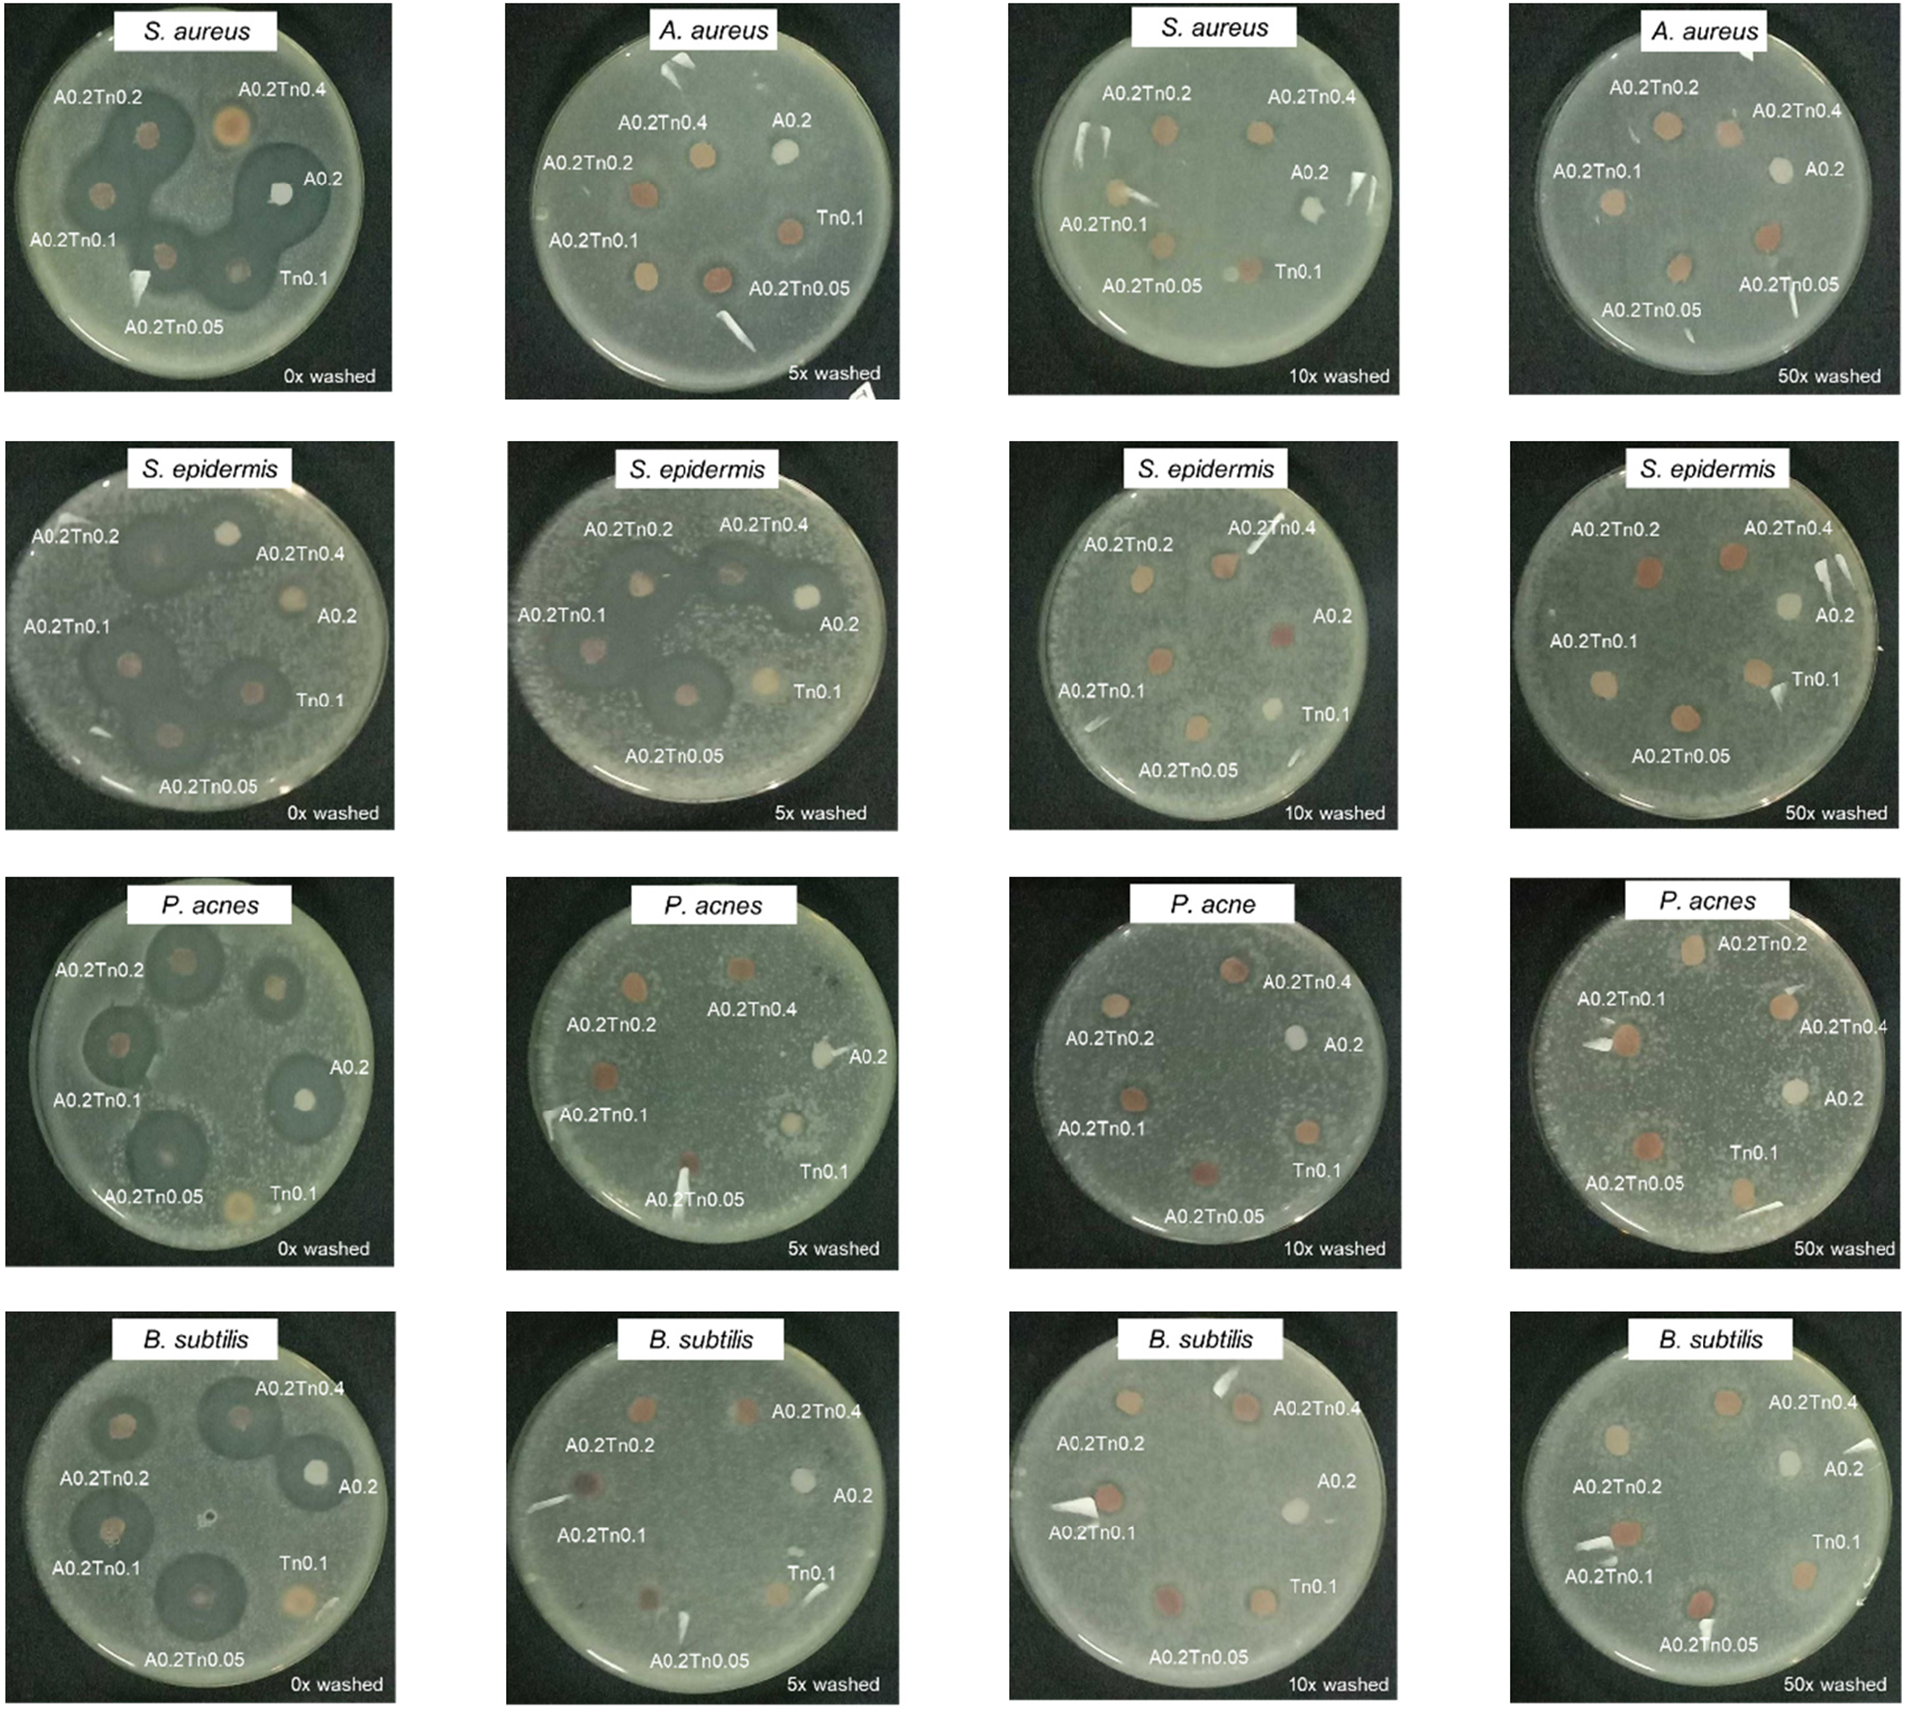
images

Open Access
ARTICLE
Tannins from Acacia mangium Bark as Natural Dyes for Textiles: Characteristics and Applications
1 Research Center for Biomass and Bioproducts, Research Organization for Life Sciences and Environment, National Research and Innovation Agency (BRIN), Jl. Raya Bogor KM 46, Cibinong, Bogor, 16911, Indonesia
2 Department of Forest Product Technology, Faculty of Forestry, IPB University, Bogor, 16680, Indonesia
3 Research Institute for Sustainable Humanosphere, Kyoto University, Uji, Kyoto, 611-0011, Japan
4 Research Center for Applied Microbiology, Research Organization for Life Sciences and Environment, National Research and Innovation Agency (BRIN), Jl. Raya Bogor KM 46, Cibinong, Bogor, 16911, Indonesia
* Corresponding Author: Maya Ismayati. Email:
(This article belongs to the Special Issue: Recent Advances on Renewable Materials)
Journal of Renewable Materials 2024, 12(9), 1625-1637. https://doi.org/10.32604/jrm.2024.054739
Received 06 June 2024; Accepted 01 August 2024; Issue published 25 September 2024
Abstract
Tannins are capable of producing natural dyes with antioxidant and antibacterial propertis, while synthetic dyes are commonly used in the textile industry, causing environmental issues like water pollution. This research aims to utilize waste tannins as natural dyes as an alternative to synthetic dyes. This study examined the effect of the extraction method on tannin properties such as phenolic content, antioxidants, and antibacterial activity. In addition, Pyrolysis Gas Chromatography‒Mass Spectrometry (Py-GCMS) analysis was used to identify the effect of extraction temperature on the chemical elucidation of tannin. The effect of tannin concentration was evaluated against four bacteria that are usually found on human skin: Staphylococcus epidermidis, Bacillus subtilis, Propionibacterium acnes, and Staphylococcus aureus. Extraction temperature significantly influences the chemical composition of tannin, which leads to different antioxidant properties. The maximum antibacterial properties of tannin were obtained at 90°C with the inhibition zone in the range of 0.9–1.0 mm against four bacteria, tannin yield of 26.59%, Gallic Acid Equivalents or total phenolic content (GAE) of 40.30 mg/g, and Radical Scavenging Activity or antioxidant activity (RSA) of 89.88%. Moreover, the concentration of tannin was significantly linear with its antibacterial properties. Tannin was successfully applied to the textile by using alum as a mordanting agent to create an antibacterial textile. The textile’s bacterial structure damage was analyzed under Field Emission Scanning Electron Microscopy (FESEM). After 50 washings, tannin-textiles with alum-modified properties remained stable compared to those without alum, with S. aureus and S. epidermidis being the most vulnerable bacteria, as confirmed by FESEM images. Hence, tannin is a feasible alternative to harmful and nondegradable synthetic dyes and antibacterial agents.Graphic Abstract
Keywords
Antimicrobial fabrics are becoming more popular as consumer health consciousness grows. According to the global market, antibacterial textiles are predicted to exceed $18.2 billion in 8 years, with a 7.4% growth rate, while they reached $10 billion in 2019 [1]. Synthetic antibacterial agents such as silver, triclosan, and quaternary ammonium salts are commercially available on the market [2]. However, the environmental issues associated with these synthetic substances have attracted the attention of researchers seeking to find more sustainable and safe alternative substances, such as forest products. Sustainability is an aspect that has become the foundation of forest utilization. Currently, nontimber forest products are being widely utilized to support the country’s economy. Chemical components present in wood are one form of nontimber forest product, such as bark, which, if processed in advance, will produce products that are value-added and environmentally friendly. In another report, Tasnim et al. [3] reported the potency of banana-derived tannins as sustainable dyes for leather. The results showed that the tannins derived from banana bunches and stem syrup may be favored as potential vegetable tanning materials in the leather-processing sector as alternatives to commercial vegetable tannins.
In Indonesia, Acacia mangium is often found in industrial plantations because of its fast-growing and adaptable nature. A. mangium is utilized in the timber, pulp and paper industries, and its bark, which is rich in tannins, is a byproduct. Currently, tannins are being widely developed for use as various environmentally friendly products, such as natural dyes, due to their natural brown color [4]. The chemical composition of tannins, which have a high phenolic content, endows them with antibacterial, antifungal, and antioxidant properties [5,6]. Hidayat et al. [7] reported that tannins from A. mangium and Acacia crassicarpa were effective at inhibiting the growth of bacteria found in human skin, such as Staphylococcus epidermidis, Bacillus subtilis, Propionibacterium acnes, and Staphylococcus aureus. These advantages have led to the ambition of replacing synthetic dyes with natural dyes and have added value as antibacterial agents. Some studies have investigated the application of tannins as dyes and antibacterial agents for leather [8,9]. It is crucial to understand the presence of antibacterial properties in tannin compounds, considering their composition and chemical makeup. However, there is a lack of research on this topic, particularly on the bark of A. mangium.
Some studies have reported the effect of the extraction process of tannins on coloring performance [10–12], yet none have evaluated the effect of the extraction process on the chemical elucidation of tannins. This evaluation is important because the antibacterial and antioxidant properties of tannins depend on the extraction conditions. To fill this research gap in the field of tannin research, this paper aimed to determine the optimum temperature at which to extract tannins with a high phenolic content and the best antioxidant and antibacterial properties for application in textiles. In addition, the effect of the tannin concentration on the antioxidant and antibacterial activities was also investigated. We believe that this research will be helpful for academia and industry to find alternatives to eco-friendly synthetic dyes with added value as antibacterial agents.
The bark of 5- to 10-year-old A. mangium plants was obtained from PT. RAPP Riau, Indonesia. Cotton fabric was purchased from a local market in Bogor, Indonesia. Alum, Na2CO3, gallic acid, Folin-Ciocalteu reagent, nutrient agar, nutrient broth, potato dextrose agar, DPPH, glutaraldehyde, cacodylate buffer, tannic acid, and alcohol were purchased from Sigma Aldrich, USA. Moreover, the bacteria Propionibacterium acnes, Staphylococcus epidermidis, Staphylococcus aureus, and Bacillus subtilis were cultivated by the Laboratorium Indonesian Culture Collection (InaCC), BRIN, Cibinong, West Java.
2.2 Tannin Extract of A. mangium
The bark of A. mangium with a wood moisture content of 12%–15% was ground using a milled hammer and sieved with 40–60 mesh. Approximately 10 grams of A. mangium powder was extracted using 200 mL of water at various temperatures (60°C, 70°C, 80°C, 90°C, and 100°C) for 8 h with a hot plate stirrer. Each extracted tannin solution was then filtered using filter paper to separate the tannin extract from the biomass. The liquid extract was freeze-dried for 4 h to obtain a powder.
Tannin extracts from different temperatures were dissolved in ethanol to a concentration of 0.5 mg/mL. Approximately 0.5 mg of extract solution was mixed with 2.5 mL of 10% folin-Ciocalteu and 2 mL of 7.5% Na2CO3. The solution was incubated for 60 min. The phenolic content was evaluated by measuring the sample solution’s absorbance at 765 nm and comparing it to gallic acid as a standard calibration curve. The analysis was conducted in triplicate.
To evaluate the effect of extraction temperature on the antioxidant activity of tannins, freeze-dried tannins were dissolved in methanol to a concentration of 1 mg/mL. Furthermore, as much as 0.2 mL of solution was mixed with 3.8 mL of 0.05 mM DPPH. DPPH was used as a control by mixing 3.8 mL of DPPH with 0.2 mL of water. The antioxidant activity was measured by reading the wavelength of the solution at 517 nm. Furthermore, the antioxidant activity was calculated by using the following equation:
where RSA is the radical scavenging activity or antioxidant activity (%), and A is the absorbance value of each control and sample.
2.5 Pyrolysis Gas Chromatography-Mass Spectrometry (Py-GCMS)
Py-GCMS was used to study the chemical composition of tannin compounds at different extraction temperatures. As much as 500 μg of tannin powder was weighed and then put into the SF PY 1-EC50 eco-cup and covered with glass wool to be pyrolyzed at 500°C for 0.1 min to breakdown lignocellulose using a multishot pyrolysis device (EGA/PY-3030D) connected (interface temperature 280°C) with a GC/MS QP-2020 NX system (Shimadzu, Tokyo, Japan). The pressure and temperature used were 20 kPa (15.9 mL/min, column flow 0.1 mL/min) at 50°C for GC (held for 1 min), the temperature was increased to 280°C (5°C/min), and the temperature was held at 280°C for 13 min [13].
2.6 Antimicrobial Activity Analysis
The effect of the extraction temperature on the antibacterial activity of the tannins was observed. Tannin from different extraction methods was dissolved in water to a concentration of 0.1 g/mL following the Hidayat et al.’s [7] protocol. The agar diffusion method was used to observe antibacterial activity against P. acnes, S. epidermidis, S. aureus, and B. subtilis. The isolated bacteria were kept at 4°C on a nutritional agar (NA) slant. A loop full of each isolate was transferred to 100 mL Erlenmeyer flasks together with 50 mL of nutrient broth (NB) media to create the inoculum. The flasks were then incubated in a Bio-Shaker BR-300 incubator for 24 h at 37°C and 100 rpm. After that, 1 × 107−1 × 108 CFU/mL of each inoculum was added to liquid NA medium at a ratio of 1% (v/v) and thoroughly mixed. A sterile petri dish was filled with bacterial mixture (20 mL). Following the solidification of the agar, a sterile cork borer was used to aseptically punch a hole with a diameter of 5 mm, and 20 µL of lignin solution was added to the well. After that, the petri dishes were incubated for 24 h at 30°C until a clear zone appeared. The effects of tannin extract on the clear inhibition zone were analyzed with analysis of variance (ANOVA), and samples showing significant differences (p < 0.05) were analyzed using Duncan’s post hoc test (α = 0.05). All analyses were performed using IBM SPSS version 22 (IBM Japan, Tokyo, Japan).
To analyze the antibacterial activity of the textiles, the bacterial mixture was added to a sterile petri dish to a volume of 20 mL. After the bacterial mixture on the agar had hardened, circular samples 5 mm in diameter, which were taken from Section 2.7, were placed on the agar surface. After that, the petri dishes were incubated for 24 h at 30°C until a clear zone appeared. Three replications of the antibacterial test were performed.
2.7 Application of Alum and Tannin
Cotton fabric 8 cm × 8 cm in size was soaked in 0.2 g/mL alum for 1 h at 90°C. Subsequently, the textiles treated with alum were immersed in tannin solution at different concentrations (0.05, 0.1, 0.2, and 0.4 g/mL) for 1 h at 40°C. The coated alum-textile was then dried at 60°C for 20 min.
2.8 Antibacterial Activity Resistance against Washing According to SNI ISO 105-C06:2010
Each fabric sample was washed with 0.3 g of detergent in 200 mL of water for 45 min. Subsequently, the fabric was dried at room temperature, and this step was designed as one cycle. To evaluate the resistance of antibacterial activity against washing, the cycle was repeated 5, 10, and 50 times. Furthermore, the antibacterial activity of the washed fabric was analyzed according to Section 2.6, while the morphology of the washed textile was observed by field emission scanning electron microscopy (FE-SEM).
2.9 Morphology Analysis of Bacteria and Fabric by FE-SEM
Tannin powder was dissolved in nutrient broth (NB) media at the same concentration to optimize the antibacterial activity. As a control, only solvent was used. Next, each bacterium was inoculated with tannins for 24 h. The sample preparation process for SEM analysis was carried out by adding 2.5% glutaraldehyde solution (1:1, v/v) for (minimum) 2 h, centrifuging (8000 rpm, 1 min), and washing with 2% tannic acid for 6 h. After that, the washing process was carried out using cacodylate buffer, 50% alcohol, 70% alcohol, and 85% alcohol sequentially with a replacement process for 2 × 10 min of storage at 4°C. Washing was continued with 95% alcohol and absolute alcohol for 20 min each at room temperature. Finally, the sample was dried by adding tert-butanol at −80°C and coated with Au coating material using an ion coater. Bacterial observations were carried out after the coating sample was placed on the sample holder and then subjected to field emission scanning electron microscopy (FE-SEM) (JEOL JSM-IT 200; MA, USA). The morphology of the bacteria was determined at magnifications of 10,000 times, 10 kV, and a working distance of 12 mm.
3.1 Effect of Temperature on the Chemical Properties of Tannins
The antimicrobial and antioxidant properties of tannins depend on the specific tannin functional group [14]. It has been reported that tannins are bound to saponins, nucleic acids, alkaloids, and polysaccharides such as cellulose, hemicellulose, and pectin. Similarly, an increase in water temperature may lead to the extraction of phenolic compounds that are attached to proteins or polysaccharides [15]. Mondal et al. [16] reported that gallol-based polymers have greater antioxidant properties than catechol-based polymers. Tannin from the bark of A. mangium is a renewable, environmentally friendly source of polyols and can be applied in various uses [17]. Therefore, it is important to analyze the phenolic types of tannin extracts.
Some pyrolysis products of phenolic compounds are presented in Table 1. Tannin polymers are fragmented into monomers such as catechol, resorcinol, pyrogallol, and benzoic acid. Catechol was reported as a major pyrolysis product from the β-ring of catechin and epicatechin [13]. In addition, pyrogallol was detected as the main pyrolysis product of gallocatechin and epigallocatechin [13,18]. Interestingly, in this study, resorcinol was found to be a major pyrolysis product that has not yet been reported. Resorcinol is only found as a minor pyrolysis product originating from A-ring condensed tannins, as reported by Ismayati et al. [13]. The decrease in total phenolics, which is possibly due to an increase in temperature resulting in denaturation, is supported by the pyrolysis data from Py-GCMS (Table 2). Resorcinol and its derivatives (resorcinol, 2-methyl; resorcinol, 5-methyl; resorcinol, 2-ethyl) decreased from 80°C to 90°C. Only one-fifth of the abundance of resorcinol was found in the extract treated at 100°C compared to the extract treated at 70°C. Cahyana et al. [19] reported that resorcinol with synthesized natural dyes (isatin derivatives) had antimicrobial activity toward S. aureus and E. coli and had the best antioxidant activity, with an IC50 of 220.43 ppm. The correlation of these pyrolysis products with antibacterial and antioxidant activity will be discussed in the next section.

3.2 Antibacterial and Antioxidant Activity of Tannin Extract Extracted at Different Temperatures
Several investigations have been reported on tannins, a family of polyphenolic chemicals present in many plants, and their potential use in smart textiles with antibacterial properties [20,21]. Bio-NIPU resins formulated with tannin extract derived from the bark of A. mangium, which serves as a sustainable substitute for hazardous polyols, have been investigated for tannin-derived compounds [22]. Table 2 shows the effect of temperature on tannin properties, such as yield, antibacterial activity, and antioxidant activity. Tannin extract from the bark of A. mangium successfully inhibited bacterial growth, as indicated by a clear zone. The highest zone of inhibition for S. aureus, S. epidermis, B. subtilis, and P. acnes, approximately 1.0 cm, was obtained from tannin extract extracted at 90°C. According to the results, the clear zone diameter of the four different bacteria gradually increased at higher temperatures of the tannin extract. Annova test results of the effect of temperature and bacteria on the clear zone showed significant differences with a level of confidence of 95%. Bacterial growth is generally inhibited by tannin extracted at 90°C, and it begins to decline at 100°C. This result is closely related to secondary metabolites that are extracted under the influence of temperature [23]. In addition, the type of solvent also had a significant influence on the antibacterial activity of tannins, as reported by Hidayat et al. [7]. It has also been reported that using 60°C water for ramie fiber application enhances the mechanical and thermal properties of crude tannin extract from A. mangium. It was impregnated into ramie fiber using tannin-based PU resin [22,24]. Water, alcohol, and 70% acetone are the most frequently used solvents for bark extraction because they are inexpensive solvents with acceptable yields [25]. According to these results, the optimal extraction method involving water (at 90°C) is expected to be applied on a pilot scale in the textile industry, which is economical, provides additional value for antibacterial activity, and is environmentally friendly. These findings confirm a study by Ispiryan et al. [26], who reported a moderate correlation between antibacterial or antioxidant activity and increasing water temperature. In a slightly different way, the extract at 80°C showed the strongest antioxidant activity. Although the relative abundance of resorcinol at 90°C was low (21.6%), the presence of benzoic acid as an organic acid increased the antibacterial properties of the tannin extract. This result confirmed the results of a previous study on the antimicrobial properties of organic acid against E. coli, Salmonella, and Staphylococcus, where the toxicity of hydrolyzed tannins was greater than that of condensed tannins [27]. Another study revealed that ellagitannins act as inhibitors of bacterial quorum sensing (QS) by modulating the virulence of pathogenic bacteria [28]. Phenolic compounds such as lignin and tannins have been widely reported to be antimicrobial agents that can penetrate bacterial cell walls (inner membranes) due to metabolic disorders and ultimately cause cell damage [6]. Physical damage to the preotic cell walls of bacteria has also been reported as a mechanism of action of tannin compounds contained in persimmon (Diospyros kaki) with catechin, catechin-3-gallate, gallocatechin, and gallocationchin-3-gallate units [29,30]. Benzoic acid has antibacterial activity by employing acid transport through the release of H+ ions into the cytoplasm of bacteria, which disrupts bacterial cell homeostasis [31]. Moreover, increasing the extraction temperature can increase the presence of carbohydrates in the extract. Carbohydrates can hinder the antibacterial effects of extracts by binding and stabilizing bacterial cell walls, thereby reducing their activity [6].
The antibacterial activity increased linearly with the yield of tannins, as shown in Table 2. A greater yield of tannins and greater antibacterial activity against four different bacteria were observed because the bark of trees that accumulate tannins is resistant to bacterial and fungal infections at high yields [23]. However, the total phenolic content expressed by the GAE does not correlate with antibacterial activity or antioxidants. This result was not consistent with the Ispiryan et al. [26] findings of, who reported that the phenolic content was strongly correlated with the antioxidant and antibacterial activities of tannins. This may be due to the release of benzoic acid from the tannins extracted at 90°C according to the molecular analysis results shown in Table 1. The components of the extracted wood, such as the primary (carbohydrate) and secondary (phenolic, extractive) metabolites, have an impact on the optimal conditions for antibacterial and antioxidant activities. Phenolic compounds act as antioxidants by interacting with free radicals, and a greater number of hydroxyl units increases the radical scavenging activity (RSA) [33]. Moreover, the key mechanism of the antibacterial activity of tannins is their ability to bind and precipitate proteins [6]. The total phenolic content, as shown by the GAE value in this study, tended to decrease with increasing extraction temperature, although the yield increased. The antioxidant activity, represented as RSA, significantly differed at the different extraction temperatures.
3.3 Effect of the Tannin Concentration and Washing on the Antibacterial Activity of the Treated Fabric Mordanted by Alum
Antibacterial activity was tested using cotton coated with only alum, only tannins, or a combination of alum and tannins at different concentrations. Tannin (0.1 g/mL) was used to cover the fabric according to Hidayat et al. [7], who reported that 0.1 g/mL of tannin has good antibacterial activity. The concentration of alum used was constant at 0.2 g/mL, while variations in tannin concentration (0.05, 0.1, 0.2, and 0.4 g/mL) were used to evaluate the effect of tannin concentration on bacterial activity. In the present study, the results in Table 3 and Fig. 1 show that alum alone coated in textiles had a greater clear zone (1.5–2 cm) than did tannin alone (0–0.6 cm) against S. aureus, S. epidermidis, P. acnes, and B. subtilis. This result was slightly lower than the Hidayat et al. [7] result. Tannin extracts derived from A. mangium in water exhibited a 0.6–0.7 cm clearance zone against S. aureus, S. epidermidis, P. acnes, and B. subtilis. Moreover, the fabric coated with tannins in this study did not exhibit activity against B. subtilis. However, these data generally proved that synthetic metals (alum) had a better ability to inhibit bacterial growth than natural metals (tannin). Alum is well known as an effective, safe, and environmentally friendly inorganic compound with a positive charge and antibacterial activity [34]. The combination of tannins and alum as antibacterial agents in the fabric resulted in a lower tannin concentration and a lower clearance zone. This result was similar to that of Cipriano-Salazar et al.[35], who tested the ability of different concentrations of tannins to inhibit rumen bacteria. This may be because a higher concentration of tannins increases the inhibition of sugar and amino acid uptake [36].

Figure 1: The inhibition diameter zones of the textiles after treatment with alum and tannins
To determine the antibacterial durability of the cotton fabric, different numbers of washing cycles (5, 10, and 50) were conducted. The antibacterial activity in Table 3 shows a significant decrease in the clear zone after washing, particularly at 5 to 50 washing cycles with a diameter of less than 0.6 cm (except for S. epidermidis until the 5th wash). Generally, the combination of alum and tannins had better antibacterial activity than the individual treatments. Weak electrostatic interactions occur when tannins are applied to textiles as crosslinkers; hence, the textiles are easily washed during laundering. The antibacterial properties of the fabric coated with alum or tannin vanished after 10 Prabhu et al.’s [11] washes. Similarly, it reported that the antibacterial activity of textiles treated with tannin alum decreased more significantly after washing 5 times. A clear zone can still be seen in the A0.2Tn0.4 fabric after 50 washes, which might be due to the strong binding of alum with tannins through covalent bonds [37]. Generally, S. aureus and S. epidermidis were more vulnerable than other bacteria, which was indicated by the greater clear zone diameter. This phenomenon will be explained by the FESEM image in the next section. Conditions such as pH, temperature, solvent, and bacteria affect the antibacterial effectiveness of tannins [38].
3.4 Morphology of the Microbial Surface after Tannin Treatment by FESEM
By implementing FESEM, the distinctive microstructure of the microbial surface area was investigated to assess the microbial surface area before and after tannin extract treatment. Fig. 2 shows the surface area of the bacteria used in this study, namely, cocci (round) and bacilli (long). In detail, S. aureus and S. epidermidis are coccus-shaped bacteria, while P. acnes and B. subtilis are bacilli. Fig. 3 shows that alum-tannins had a greater effect on the structure of coccus-shaped bacteria than on that of Bacillus-shaped bacteria after treatment with alum (0.2 g/mL) in combination with tannin (0.4 g/mL). Compared with the other two bacilli, S. aureus and S. epidermidis are coccus-shaped bacteria that cause structural damage in a tannin-alum solution: P. acnes and B. subtilis. This result was similar to that shown in Table 3, where the clear zone diameters of S. aureus and S. epidermidis were greater than those of P. acnes and B. subtilis. Similar to previous research, the resistance of S. aureus bacteria was lower than that of B. subtilis. Bacteria with a coccus shape are smaller than Bacillus-shaped bacteria, making it easier for bacteria to absorb tannin compounds [7,31].

Figure 2: FESEM images of the control bacterium B. subtilis (a). P. acnes (b). S. epidermidis (c). and S. aureus (d) at 10.000× magnification

Figure 3: FESEM images of the effect of the bacteria B. subtilis (a), P. acnes (b), S. epidermidis (c), and S. aureus (d) at a magnification of 10.000 times after the addition of alum (0.2 g/mL) and tannin (0.4 g/mL)
Tannin derived from A. mangium has the potential to be used as an antibacterial agent because its chemical properties and antibacterial activity depend on temperature during extraction and the tannin concentration. According to the Py-GCMS data, resorcinol was found to be a major pyrolysis product of all the tannins extracted at 60°C–100°C, while benzoic acid was found only in the tannin extract at 90°C. The tannic extract from 90°C had the maximum zone of inhibition for S. aureus, S. epidermis, B. subtilis, and P. acnes, approximately 1.0 cm. The findings showed that at higher temperatures of tannin extract, the clear zone diameter of four distinct bacteria progressively increased. The antibacterial activity of tannins increased with increasing concentrations of tannins. In addition, the tannin yield was positively correlated with the antibacterial activity. However, it was not linear with respect to the antioxidant content (shown as RSA) or total phenolic content (expressed as GAE). The application of tannins to the fabric showed that combining tannins with alum as a mordant resulted in increased antibacterial activity and durability after 50 washes, while the activity depended on the tannin concentration. A larger clear zone diameter indicated that S. aureus and S. epidermidis were generally more susceptible than B. subtilis and P. acnes. This result was proven by FESEM images of bacterial morphology before and after treatment with alum-tannin, where more damaged surfaces of bacteria were clearly observed for S. aureus and S. epidermidis after alum-tannin in addition to the bacteria. We believe that these results can serve as a reference for academia and the textile industry for developing sustainable antibacterial agents.
Acknowledgement: The authors thank the Advanced Characterization Laboratories Cibinong—Integrated Laboratory of Bioproduct, BRIN through E-Layanan Sains (ELSA) for the facilities and for providing scientific and technical support.
Funding Statement: This research was funded by the JASTIP-RISH 2022 (S-08) and RIIM 2023 Batch 4, National Research and Innovation Agency (BRIN) Indonesia.
Author Contributions: The authors confirm their contributions to the paper as follows: Maya Ismayati, Nissa Nurfajrin Solihat, Yuki Tobimatsu, Deni Zulfiana, and Fifi Melinda Setiawan conceived the experiments; Maya Ismayati, Fifi Melinda Setiawan, Nissa Nurfajrin, Deni Zulfiana, and Wasrin Syafii collected the data and interpreted the results. All authors reviewed the results and approved the final version of the manuscript.
Availability of Data and Materials: The authors confirm that the data supporting the findings of this study are available within the article.
Ethics Approval: Not applicable.
Conflicts of Interest: The authors declare that they have no conflicts of interest to report regarding the present study.
References
1. Narune A, Prasad E. Antimicrobial textiles market by fabric (polyester, polyamide, cotton, and others), active agent (metal & metallic salts, synthetic organic compounds, and bio-based agents), and application (medical textiles, home textiles, apparels, and others): global opportunity analysis and industry forecast 2020–2027; 2020. Available from: https://www.alliedmarketresearch.com/antimicrobial-textiles-market-A07935. [Accessed 2024]. [Google Scholar]
2. Morais DS, Guedes RM, Lopes MA. Antimicrobial approaches for textiles: from research to market. Materials. 2016;9(6):498. doi:10.3390/ma9060498. [Google Scholar] [PubMed] [CrossRef]
3. Tasnim KT, Debnath A, Uddin MT, Alam MA, Razzaq MA, Zaman SZ, et al. Comparative evaluation of tannin from banana bunch and stem syrup for leather processing. Heliyon. 2024;10(11):e31787. doi:10.1016/j.heliyon.2024.e31787. [Google Scholar] [PubMed] [CrossRef]
4. Hong KH. Effects of tannin mordanting on coloring and functionalities of wool fabrics dyed with spent coffee grounds. Fashion Text. 2018;5(1):33. doi:10.1186/s40691-018-0151-3. [Google Scholar] [CrossRef]
5. Lykidou S, Pashou M, Vouvoudi E, Nikolaidis N. Study on the dyeing properties of curcumin on natural and synthetic fibers and antioxidant and antibacterial activities. Fibers Polym. 2021;22(12):3336–42. doi:10.1007/s12221-021-0412-4. [Google Scholar] [CrossRef]
6. Solihat NN, Hidayat AF, Ilyas RA, Thiagamani SMK, Azeele NIW, Sari FP, et al. Recent antibacterial agents from biomass derivatives: characteristics and applications. J Bioresour Bioprod. 2024;9:283–309. doi:10.1016/j.jobab.2024.02.002. [Google Scholar] [CrossRef]
7. Hidayat AF, Solihat NN, Zulfiana D, Anita SH, Oktaviani M, Ismayati M, et al. Solvent effect on revealing antibacterial potency of lignin and tannin from Acacia mangium and Acacia crassicarpa. AIP Conf Proc. 2024;2973:030004. doi:10.1063/5.0184578. [Google Scholar] [CrossRef]
8. China CR, Nyandoro SS, Munissi JJE, Maguta MM, Meyer M, Schroepfer M. Tanning capacity of Tessmannia burttii extracts: the potential eco-friendly tanning agents for the leather industry. J Leather Sci Eng. 2021;3(1):1–9. doi:10.1186/s42825-021-00055-2. [Google Scholar] [CrossRef]
9. Fatema Tuj Z, Shakil MSR, Aktar MS, Rahman S, Ahmed S. A novel vegetable tannin for eco-leather production: separation, characterization and application of facile valorized indigenous Acacia nilotica bark extract. Bioresour Technol Rep. 2023;23:1–12. doi:10.1016/j.biteb.2023.101591. [Google Scholar] [CrossRef]
10. Basri E, Saefudin. Waste extracts from forest plants and their application as natural coloring for fabrics. IOP Conf Ser: Mater Sci Eng. 2020;935(1):1–8. doi:10.1088/1757-899X/935/1/012001. [Google Scholar] [CrossRef]
11. Prabhu KH, Teli MD. Eco-dyeing using Tamarindus indica L. seed coat tannin as a natural mordant for textiles with antibacterial activity. J Saudi Chem Soc. 2014;18(6):864–72. doi:10.1016/j.jscs.2011.10.014. [Google Scholar] [CrossRef]
12. Hayat T, Adeel S, Fazal Ur R, Batool F, Amin N, Ahmad T, et al. Waste black tea leaves (Camelia sinensis) as a sustainable source of tannin natural colorant for biotreated silk dyeing. Environ Sci Pollut Res Int. 2022;29(16):24035–48. doi:10.1007/s11356-021-17341-5. [Google Scholar] [PubMed] [CrossRef]
13. Ismayati M, Nakagawa-izumi A, Ohi H. Structural elucidation of condensed tannin from the bark waste of Acacia crassicarpa plantation wood in Indonesia. J Wood Sci. 2017;63(4):350–9. doi:10.1007/s10086-017-1633-4. [Google Scholar] [CrossRef]
14. Iqbal N, Poór P. Plant protection by tannins depends on defence-related phytohormones. J Plant Growth Regul. 2024;1–18. doi:10.1007/s00344-024-11291-1. [Google Scholar] [CrossRef]
15. ChaichiSemsari M, MaheriSis N, Sadaghian M, Eshratkhah B, Hassanpour S. Effects of administration of industrial tannins on nutrient excretion parameters during naturally acquired mixed nematode infections in Moghani sheep. J Am Sci. 2011;7:245–8. [Google Scholar]
16. Mondal A, Pal A, Sarkar S, Datta R, De P. Antioxidant polymers with phenolic pendants for the mitigation of cellular oxidative stress. Biomacromolecules. 2024;25(3):1649–59. doi:10.1021/acs.biomac.3c01193. [Google Scholar] [PubMed] [CrossRef]
17. Aristri MA, Sari RK, Lubis MAR, Laksana RPB, Antov P, Iswanto AH, et al. Eco-friendly tannin-based non-isocyanate polyurethane resins for the modification of ramie (Boehmeria nivea L.) fibers. Polymers. 2023;15(6):1–21. doi:10.3390/polym15061492. [Google Scholar] [PubMed] [CrossRef]
18. Ohara S, Yasuta Y, Ohi H. Structure Elucidation of condensed tannins from barks by pyrolysis/gas chromatography. Holzforschung. 2003;57(2):145–9. doi:10.1515/HF.2003.023. [Google Scholar] [CrossRef]
19. Cahyana AH, Liandi AR, Ongkowidjawa Y. Iodine-catalyzed synthesis, antibacterial, and antioxidant activity of isatin derivatives. Indones J Chem. 2024;24(2):567. doi:10.22146/ijc.84113. [Google Scholar] [CrossRef]
20. Ismayati M, Solihat NN, Sari FP. Eucalyptus bark tannin for green chemistry agent. In: Lee SH, Lum WC, Antov P, Krišťák Ľ, Rahandi Lubis MA, Fatriasari W, editors. Eucalyptus. Nature Singapore: Springer; 2024. p. 137–61. [Google Scholar]
21. Hagaggi NSA, Abdul-Raouf UM, Radwan TAA. Variation of antibacterial and antioxidant secondary metabolites and volatiles in leaf and callus extracts of Phulai (Acacia modesta Wall.). BMC Plant Biol. 2024;24(1):93. doi:10.1186/s12870-024-04747-9. [Google Scholar] [PubMed] [CrossRef]
22. Aristri MA, Lubis MAR, Sari RK, Kristak L, Iswanto AH, Mardawati E, et al. Preparation and characterization of non-isocyanate polyurethane resins derived from tannin of Acacia mangium bark for the modification of ramie fibers. Cent Eur For J. 2023;69(2):77–88. [Google Scholar]
23. Pizzi A, Laborie M-P, Candan Z. A review on sources, extractions and analysis methods of a sustainable biomaterial: tannins. J Renew Mater. 2024;12(3):397–425. doi:10.32604/jrm.2023.046074. [Google Scholar] [CrossRef]
24. Aristri MA, Lubis MAR, Laksana RPB, Sari RK, Iswanto AH, Kristak L, et al. Thermal and mechanical performance of ramie fibers modified with polyurethane resins derived from acacia mangium bark tannin. J Mater Res Technol. 2022;18:2413–27. doi:10.1016/j.jmrt.2022.03.131. [Google Scholar] [CrossRef]
25. Szmechtyk T, Małecka M. Phytochemicals from bark extracts and their applicability in the synthesis of thermosetting polymers: an overview. Materials. 2024;17(9):2123. doi:10.3390/ma17092123. [Google Scholar] [PubMed] [CrossRef]
26. Ispiryan A, Atkociuniene V, Makstutiene N, Sarkinas A, Salaseviciene A, Urbonaviciene D, et al. Correlation between antimicrobial activity values and total phenolic content/antioxidant activity in Rubus idaeus L. Plants. 2024;13(4):504. doi:10.3390/plants13040504. [Google Scholar] [PubMed] [CrossRef]
27. Kavya A, Devasena B, Suryanarayana MVAN, Kalyana Chakravarthi M, Bhaskara Reddy GV, Nagi Reddy G. In vitro evaluation of antimicrobial activity of selected organic acids against E. coli, Salmonella and Staphylococcus. Int J Vet Sci Anim Husb. 2024;SP-9(1):668–71. [Google Scholar]
28. Mathee K, Adonizio AL, Ausubel F, Clardy J, Bennett B, Downum K. Ellagitannins as inhibitors of bacterial quorum sensing. USA; 2009. U.S. Patent Application No. 12/922,555. [Google Scholar]
29. Liu M, Feng M, Yang K, Cao Y, Zhang J, Xu J, et al. Transcriptomic and metabolomic analyses reveal antibacterial mechanism of astringent persimmon tannin against Methicillin-resistant Staphylococcus aureus isolated from pork. Food Chem. 2020;309:125692. doi:10.1016/j.foodchem.2019.125692. [Google Scholar] [PubMed] [CrossRef]
30. Pizzi A. Tannins medical/pharmacological and related applications: a critical review. Sustain Chem Pharm. 2021;22:100481. doi:10.1016/j.scp.2021.100481. [Google Scholar] [CrossRef]
31. Park E-S, Moon W-S, Song M-J, Kim M-N, Chung K-H, Yoon J-S. Antimicrobial activity of phenol and benzoic acid derivatives. Int Biodeterior Biodegradation. 2001;47(4):209–14. doi:10.1016/S0964-8305(01)00058-0. [Google Scholar] [CrossRef]
32. Ismayati M, Fatah NAN, Ernawati EE, Juliandri, Kusumaningrum WB, Lubis MAR, et al. Antioxidant and UV-blocking activity of PVA/tannin-based bioplastics in food packaging application. Int J Biol Macromol. 2024;257:128332. doi:10.1016/j.ijbiomac.2023.128332. [Google Scholar] [PubMed] [CrossRef]
33. Vo QV, Thuy Hoa DT, Hoa NT, Tran MD, Mechler A. The radical scavenging activity of monocaffeoylquinic acids: the role of neighboring hydroxyl groups and pH levels. RSC Adv. 2024;14(6):4179–87. doi:10.1039/D3RA08460D. [Google Scholar] [PubMed] [CrossRef]
34. Al-Khikani F, Zaraa D, Abbas H, Musa H, Dahir H, Musa H, et al. Evaluation the antibacterial activity of potassium aluminum sulphate (alum) combined with other antibiotics. Microbes Infect Dis. 2023;5(3):1190–1197. doi:10.21608/mid.2023.206322.1514. [Google Scholar] [CrossRef]
35. Cipriano-Salazar M, Rojas-Hernandez S, Olivares-Perez J, Jimenez-Guillen R, Cruz-Lagunas B, Camacho-Diaz LM, et al. Antibacterial activities of tannic acid against isolated ruminal bacteria from sheep. Microb Pathog. 2018;117:255–8. doi:10.1016/j.micpath.2018.01.045. [Google Scholar] [PubMed] [CrossRef]
36. Pandey A, Negi PS. Phytochemical composition, in vitro antioxidant activity and antibacterial mechanisms of Neolamarckia cadamba fruits extracts. Nat Prod Res. 2018;32(10):1189–92. doi:10.1080/14786419.2017.1323209. [Google Scholar] [PubMed] [CrossRef]
37. Madhan B, Rathinam A, Siva M, Sayeed S, Rao JR, Nair BU. Interaction of aluminum and hydrolysable tannin polyphenols: an approach to understand the mechanism of aluminum vegetable combination tannage. J Am Leather Chem Assoc. 2006;101(9):317–23. [Google Scholar]
38. Kaczmarek B. Tannic acid with antiviral and antibacterial activity as a promising component of biomaterials–a minireview. Materials. 2020;13(4):1–13. doi:10.3390/ma13143224. [Google Scholar] [PubMed] [CrossRef]
Cite This Article
Copyright © 2024 The Author(s). Published by Tech Science Press.This work is licensed under a Creative Commons Attribution 4.0 International License , which permits unrestricted use, distribution, and reproduction in any medium, provided the original work is properly cited.


Submit a Paper
Propose a Special lssue
View Full Text
Download PDF
Downloads
Citation Tools